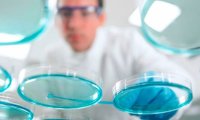
Великобритания ведет переговоры с ОАЭ о поддержке национального фонда медико-биологических наук

Великобритания ведет переговоры с ОАЭ о поддержке национального фонда медико-биологических наук
Британские министры ведут переговоры с суверенным фондом Объединенных Арабских Эмиратов о поддержке новой национальной инвестиционной программы стоимостью в сотни миллионов фунтов для стимулирования...














